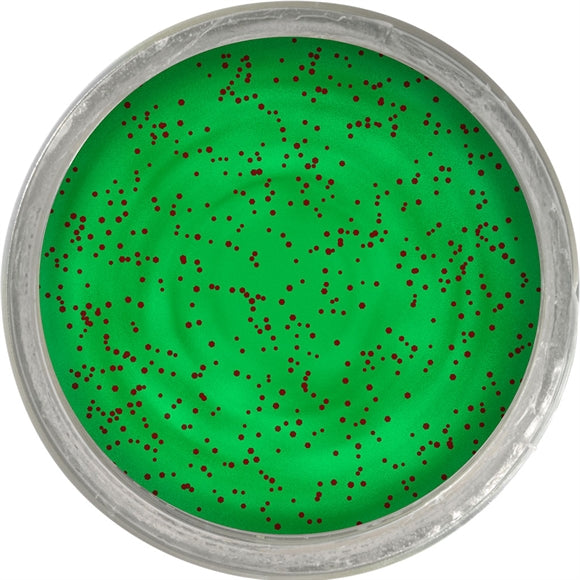

Berkley PowerBait Apple Jack - Apple Jack er i restordre og afsendes så snart det er tilbage på lager.
Kunne ikke indlæse tilgængeligheden af afhentning
Beskrivelse
Beskrivelse
Derudover kan ørreddejen fiskes på mange forskellige måder. De mest brugte fiskeformer er flåd fiskeri, hvor man enden lader dejen ligge under et flåd eller langsom inspinning ved hjælp af bombardaflåd. Metoder som bund fiskeri uden flåd og ubelastet overflade fiskeri, har også vist sig meget effektive.
Hos Jafi har vi et stort udvalg af Powerbait, så du kan finde de smage og farver du tror allermest på.
Levering og returnering
Levering og returnering
Levering
Bestiller du inden kl. 13.00 på hverdage, sender vi din ordre samme dag. Bestiller du efter kl. 13.00, bliver ordren afsendt næste hverdag. Dette gælder kun for varer, som er på lager i butikken – varens lokation kan ses lige under varens pris.
Vælg levering til pakkeshop, hjemmelevering eller afhent din ordre i vores fysiske butik.
Returnering
Der medfølger altid en returlabel, så du nemt kan sende din ordre retur, hvis du fortryder dit køb.
Prismatch
Prismatch
Har du set en vare billigere?
Hos JAFI vil vi gerne sikre, at vores kunder gør den bedste handel. Derfor imødekommer vi ofte prisen inden du køber varen, hvis du finder en identisk vare billigere hos en anden dansk forhandler. For at vi imødekommer en lavere pris, skal specifikke betingelser være opfyldt. Læs mere.
Betaling og sikkerhed
Betaling og sikkerhed
For at beskytte dine kortoplysninger håndteres betalingen af en certificeret og godkendt leverandør af betalingsmoduler, som sørger for at dine oplysninger bliver krypteret, så ingen kan få adgang til dine kortoplysninger.